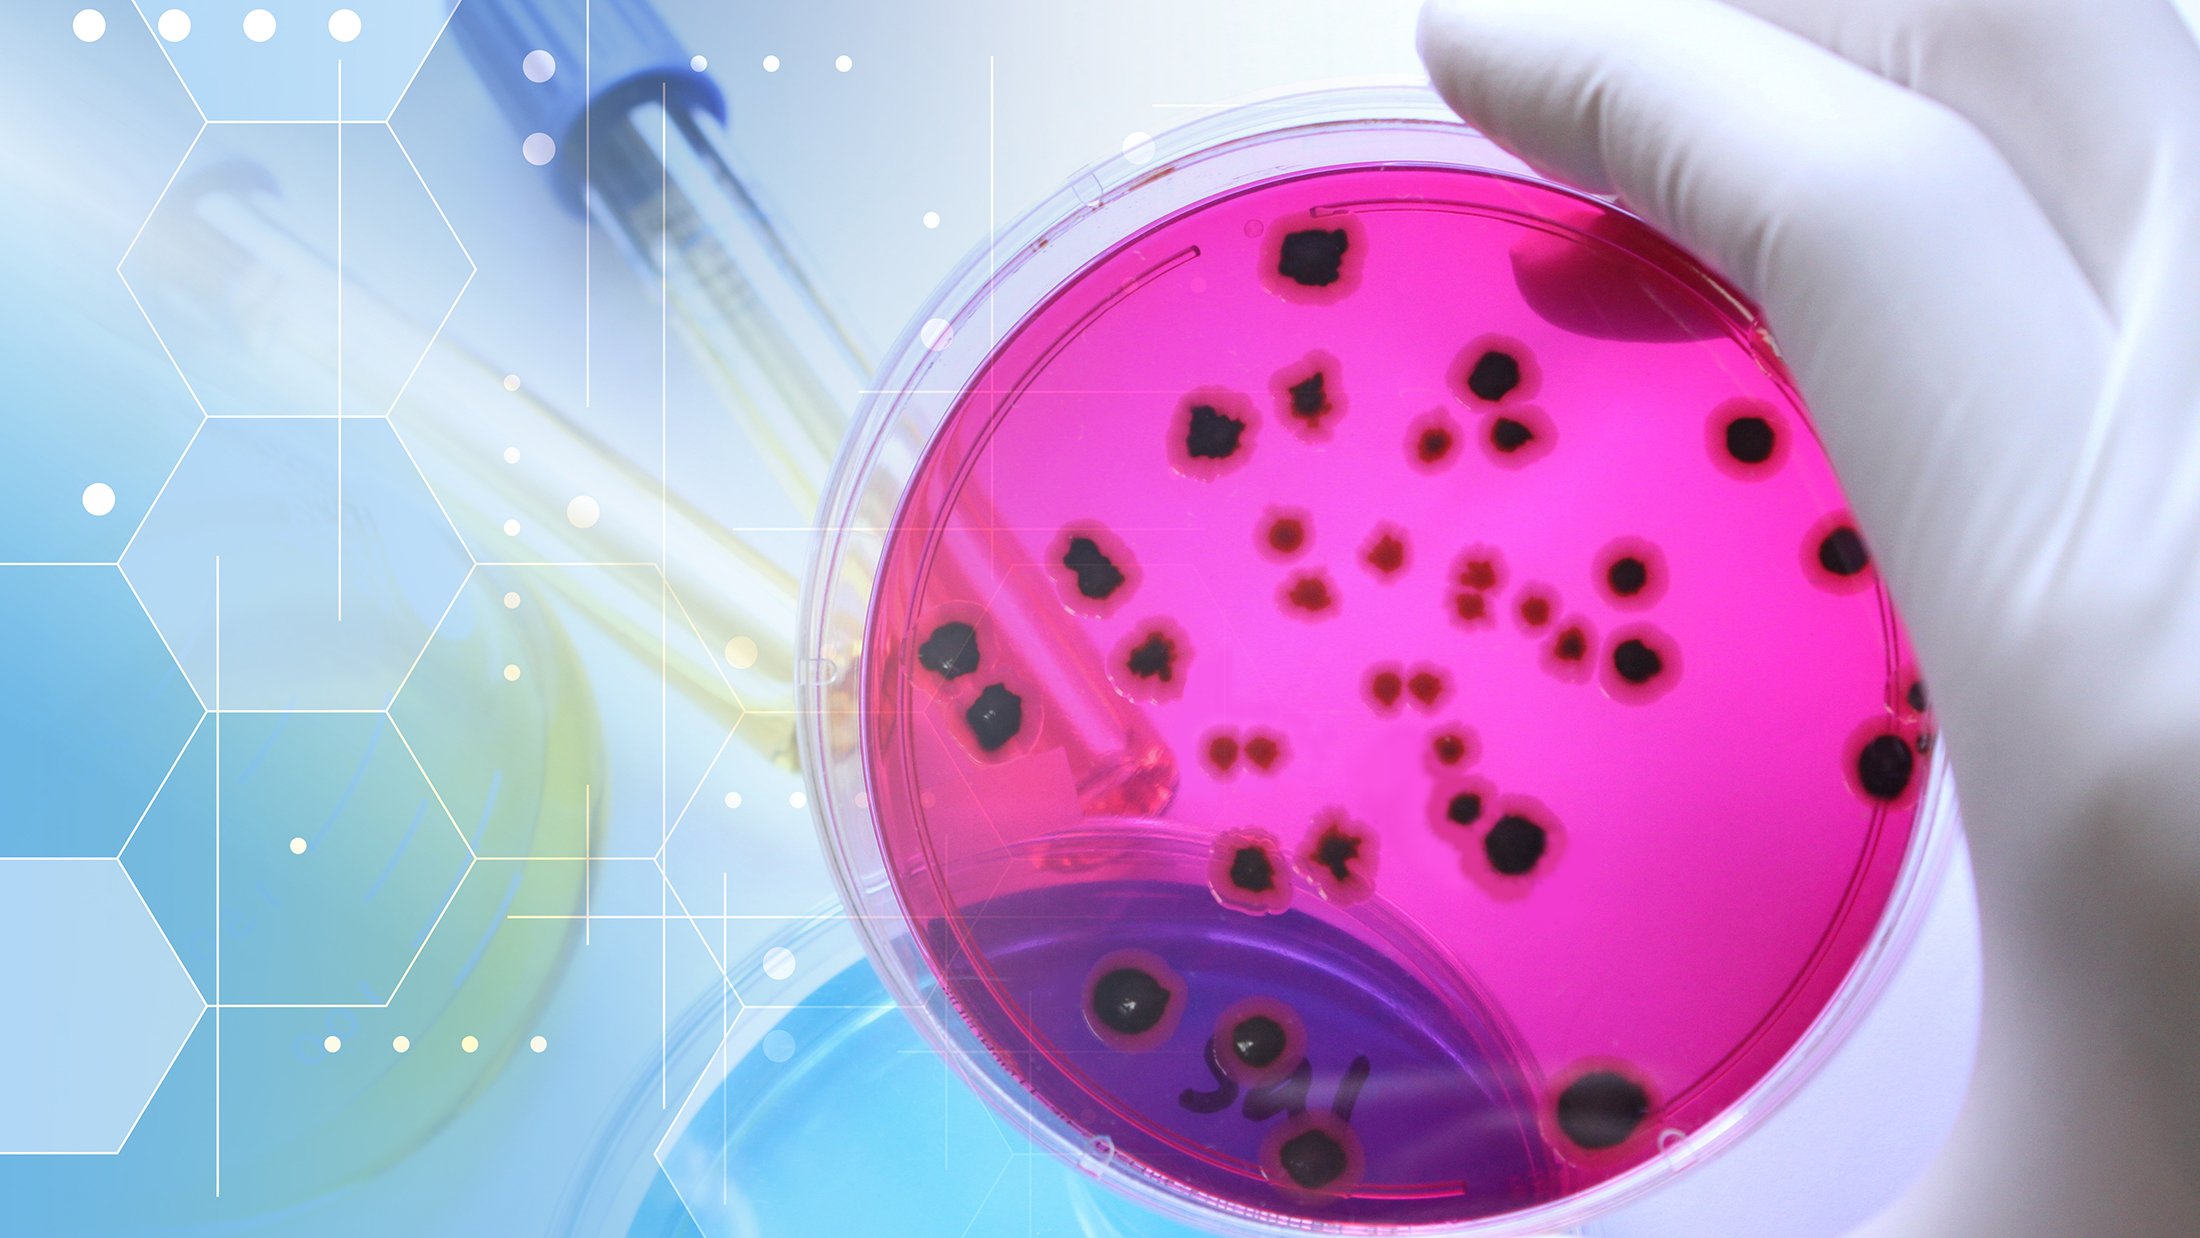
Salmonella in a petri dish

Now home to IFT FIRST – Be a part of the solutions and conversations helping to shape the future of food
IFT FIRST is where it happens. Register Now!
Food Safety
Food safety underpins public trust and the integrity of the global food supply. IFT coverage examines the science, systems, and practices that prevent contamination, manage risk, and protect public health—spanning microbiology, preventive controls, regulatory frameworks, and emerging challenges across the food value chain.

Inside AI’s Role in Food Safety
Read the in-depth article on how AI is shifting food safety from detection to prediction, then explore expert interviews with insights from Jeff Varcoe, Hal King, Willette Crawford, Bill Marler, and others.
Pathogens
Foodborne pathogens remain a central driver of food safety risk and public health concern. IFT coverage analyzes pathogen behavior, control measures, and prevention strategies across the food system—from production through processing and distribution.

Feb 16, 2026
The Effects of Essential Oils Against Salmonella
A review finds that essential oils at subinhibitory concentrations can disrupt quorum sensing, biofilm formation, and virulence gene expression in Salmonella.
Comprehensive Reviews in Food Science and Food Safety

Jun 16, 2025
Insights on Recalls, Risks, and Resilience
Three leading food safety experts explore why food safety recalls are happening, what risks might be looming, and what businesses can do to strengthen resilience.
Omnivore Podcast

Jun 06, 2025
Getting Real With Pathogen Control
How to understand and apply core management strategies for microbial control in the food processing plant.
Food Technology Magazine

Mar 21, 2025
Food Safety Meets Digital Transformation
An overview of the digital transformation tools available to help enhance food safety and the challenges that come with applying them.
Food Technology Magazine

Nov 06, 2024
Outlook 2025: Technology Trends
A forecast of the trending food and beverage technologies for 2025 and beyond.
Food Technology Magazine

Dec 20, 2023
Pathogens: The Unusual Suspects
Some “not-so-popular but deadly few” pathogenic agents are responsible for causing about 80% of foodborne illnesses and more than 50% of associated mortalities annually in the United States.
Food Technology Magazine
Chemical Additives and Allergens
Chemical hazards—including additives and allergens—require rigorous scientific assessment and control. IFT coverage examines how manufacturers manage these risks through formulation oversight, processing controls, testing, labeling, and regulatory compliance to protect consumers and ensure product safety.

Feb 17, 2026
Revisiting GRAS
IFT's CSTO shares five priorities to strengthen how FDA evaluates food additives already on the market.
Brain Food Blog

Dec 08, 2025
Click Chemistry Residue Testing
Click chemistry has emerged as a novel solution, offering rapid, specific, and ultrasensitive detection of food chemical residues, such as pesticides, antibiotics, and hormones.
Comprehensive Reviews in Food Science and Food Safety

Oct 02, 2025
How To Manage Food Allergens
How food manufacturers can better manage and control the Big Nine food allergens to ensure food safety.
Food Technology Magazine

Feb 03, 2025
Red-Hot Food Dye Substitutes
IFT’s Renee Leber delves into why color reformulations can be challenging, and what manufacturers need to keep top of mind when adjusting colors in various applications.
Omnivore Podcast

Jul 26, 2024
Food R&D: Assessing Risk Conflict
As regulators reconsider the risks of several common food additives, companies must grapple with a range of potential product development challenges.
Food Technology Magazine

Feb 04, 2024
Best Practices for Chemical Hazards
Expert tips on best practices to help mitigate food chemical hazard risks, including PFAS, BVO, and heavy metals.
Food Technology Magazine
Operations
In food manufacturing, food safety depends on integrated management systems and preventive controls. IFT coverage examines how HACCP, process control systems, digital transformation, sanitation practices, testing and auditing, supply chain verification, workforce training, and food safety culture work together to identify hazards, maintain control, and ensure safe, compliant production.

Jan 28, 2026
A Practical Guide to EMPs
The latest insights on the role of environmental monitoring programs, their regulatory basis, and how zoning helps identify and control environmental pathogen risks.
Food Technology Magazine

Dec 11, 2025
Antibacterial Food Packaging
Antibacterial silver food packaging is emerging as a new and effective means of extending food shelf life and controlling foodborne pathogen contamination.
Comprehensive Reviews in Food Science and Food Safety

Jul 09, 2025
Spread the Safety: Making Nut Butters
A look at the science, food safety risks, and processing steps involved in nut butter manufacturing.
Food Technology Magazine

Jun 16, 2025
Insights on Recalls, Risks, and Resilience
Three leading food safety experts explore why recalls are happening, what risks might be looming, and what businesses can do to strengthen resilience.
Omnivore Podcast

Mar 21, 2025
Food Safety Meets Digital Transformation
An overview of the digital transformation tools available to help enhance food safety and the challenges that come with applying them.
Food Technology Magazine

Feb 05, 2025
Better Process Validation
Validating food safety preventive controls is key to addressing processing hazards.
Food Technology Magazine
Traceability
Traceability supports rapid response, accountability, and transparency across the food supply chain. IFT coverage examines traceability frameworks, standards, data systems, and supply chain design considerations that strengthen recall readiness and oversight.

Feb 16, 2026
AI, IoT Improve Cold Chain Safety
Industry 4.0 technologies such as IoT and AI are transforming cold chain management with real-time monitoring, automation, and predictive food safety insights.
Comprehensive Reviews in Food Science and Food Safety

Aug 21, 2025
Advancing Safety in the Seafood Supply Chain
Coordinated traceability, supported by IFT and international standards, is making seafood safer, more sustainable, and better regulated worldwide.
Brain Food Blog

Jun 23, 2025
Time to Act on Traceability
Food safety experts discuss the FDA’s traceability rule delay, what’s still holding the industry back, and why companies need to act now—not wait.
Omnivore Podcast

Jun 02, 2025
FTR: Industry Must Step Up
Experts advocate for the food industry to step up the pace in implementing enhanced traceability systems, despite FDA's deadline extension to the Food Traceability Rule (FTR).
Food Technology Magazine

Jul 24, 2024
What’s in Your Traceability Tech Stack?
Companies in the food value chain are finding an array of tech-enabled solutions to boost their traceability programs. But how to choose which solutions are right for your operation?
Food Technology Magazine

Mar 01, 2024
Smart Steps to Peak Traceability
Creating an effective road map to advance your food traceability program is key to overcoming data, process, and stakeholder challenges.
Food Technology Magazine
Regulation and Policy
Food safety regulation establishes the framework for protecting public health and enabling commerce. IFT coverage analyzes regulatory requirements, enforcement approaches, and evolving policy considerations that shape food safety systems globally.

Feb 17, 2026
Revisiting GRAS
IFT's CSTO shares five priorities to strengthen how FDA evaluates food additives already on the market.
Brain Food Blog

Aug 11, 2025
MAHA at IFT FIRST
Martin Hahn and Maha Tahiri explore how the MAHA agenda could reshape formulation, labeling, and ingredient safety strategies across the food industry in this live session recorded at IFT FIRST.
Omnivore Podcast

May 05, 2025
GRAS Reform
Food safety and regulatory expert Steven Gendel talks about how the GRAS process really works, what's driving calls for reform, and what a more transparent system might look like.
Omnivore Podcast

Apr 25, 2025
Rethinking GRAS Requires More Resources
A food safety expert examines the implications of proposed changes to the GRAS system. emphasizing the need for increased resources for the FDA.
Food Technology Magazine

Jul 26, 2024
Food R&D: Assessing Risk Conflict
As regulatory and legislative bodies reconsider the risks of several common food additives, companies must grapple with a range of potential product development challenges.
Food Technology Magazine

Jan 19, 2024
Championing Food Safety Standards Worldwide
As the U.N.'s Codex Alimentarius Commission marks 60 years, IFT describes its impact on the global food system and why IFT members should get involved.
Brain Food Blog
Technology
Technology is reshaping how food safety risks are identified, monitored, and controlled. IFT coverage explores digital tools, automation, and emerging technologies that enhance detection, prevention, and decision-making across food safety systems.

Jun 01, 2026
Can AI Improve Food Safety?
AI is helping food companies predict contamination risks earlier, but human judgment, data quality, and accountability remain critical to making safe decisions.
Food Technology Magazine

Feb 26, 2026
Light-Based Tech for Low-Moisture Food Safety
Researchers examine light-based technologies as alternatives to thermal treatments for controlling microbial contamination in low-moisture foods.
Comprehensive Reviews in Food Science and Food Safety

Mar 21, 2025
Food Safety Meets Digital Transformation
An overview of the digital transformation tools available to help enhance food safety and the challenges that come with applying them.
Food Technology Magazine

Dec 30, 2024
Food Safety Tech Game-Changers
Process authority Larry Keener talks about three game-changing food safety technologies and how they are helping the food industry beat back foodborne pathogens.
Omnivore Podcast

Nov 20, 2024
Making Waves
A pioneering researcher is shaping the future of food processing through the transformative use of high-intensity ultrasound.
Brain Food Blog

Nov 06, 2024
Outlook 2025: Technology Trends
A forecast of the trending food and beverage technologies in 2025 and beyond.
Food Technology Magazine
More Trends & Learning
Looking for more content to stay on top of trends and learning?

Become a Member Today
Get discounts on courses and IFT FIRST, make new connections through Member Connect, and access publications and journals with an IFT Membership.

Subscribe to Food Technology
Food Technology is the leading publication exploring the intersection of business, science, and technology.
